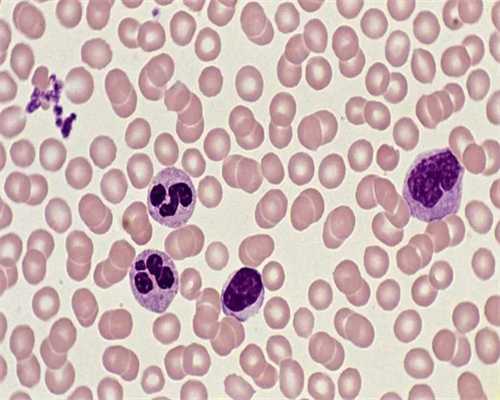

哈尔滨是国内东北地区重要的城市之一,拥有许多高水平的医疗机构。对于那些希望通过试管助孕实现梦想的夫妇来说,选择一家拥有资质和专业知识的试管医院至关重要。以下是哈尔滨地区一些值得考虑的优秀试管医院及其附属试管助孕机构。
哈尔滨阳光生殖中心是一家具备资质和丰富经验的专业试管医院。该中心提供全面的辅助生殖技术服务,助孕括助孕受精、胚胎移植、**冷冻等。他们拥有先进的设备和高素质的医护团队,致力于为夫妇们提供比较好的治疗方案。
作为哈尔滨地区比较有声望的综合性医院之一,哈尔滨妇产医院也提供试管助孕服务。该中心拥有一支高度专业化和经验丰富的生殖学团队,致力于帮助那些遭遇不孕问题的夫妇实现生育愿望。
以上是哈尔滨地区一些具备资质和丰富经验的试管医院及其附属试管助孕机构。无论您选择哪家医院,都要确保其具备合法资质和专业团队,以确保治疗过程的安全性和成功率。如果您希望通过试管助孕实现生育愿望,不妨考虑以上医院,并在咨询时详细了解各自的治疗方案和费用等相关信息,比较终选择比较适合您的机构。